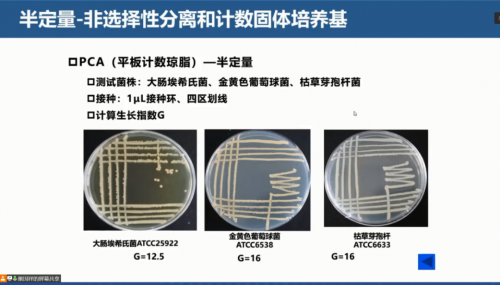

食品伙伴網(wǎng)訊 2022年1月12-13日,由食品伙伴網(wǎng)主辦的“食品微生物實(shí)驗(yàn)室技能提升培訓(xùn)班”線(xiàn)上直播圓滿(mǎn)結(jié)束。
本次培訓(xùn)邀請(qǐng)到青島海關(guān)技術(shù)中心的相關(guān)專(zhuān)家、青島市食品藥品檢驗(yàn)研究院食品部 趙海峰 高級(jí)工程師、“野獸”老師、揚(yáng)州市疾病預(yù)防控制中心 巢國(guó)祥 主任醫(yī)師為大家分享“微生物實(shí)驗(yàn)室人員要求與管理專(zhuān)題”、“微生物實(shí)驗(yàn)室設(shè)備管理專(zhuān)題”、“實(shí)驗(yàn)室生物安全專(zhuān)題”和“微生物實(shí)驗(yàn)室能力驗(yàn)證專(zhuān)題”等四大專(zhuān)題知識(shí)干貨。
來(lái)自全國(guó)各地檢測(cè)行業(yè)的近200名學(xué)員參加了此次線(xiàn)上培訓(xùn)!
下面就跟小編一起來(lái)看看本次培訓(xùn)的精彩內(nèi)容吧!
1.12日精彩內(nèi)容
微生物實(shí)驗(yàn)室人員要求與管理專(zhuān)題



12日上午9:00,由青島海關(guān)技術(shù)中心專(zhuān)家?guī)?lái)了“微生物實(shí)驗(yàn)室人員要求與管理”的專(zhuān)題報(bào)告。老師首先從微生物實(shí)驗(yàn)室人員資質(zhì)要求、微生物實(shí)驗(yàn)室人員能力考核與培訓(xùn)要求、微生物實(shí)驗(yàn)室人員質(zhì)量控制等三個(gè)方面展開(kāi),然后對(duì)學(xué)員們提出的問(wèn)題,進(jìn)行了一一的講解,讓學(xué)員對(duì)于實(shí)驗(yàn)室人員要求與管理有了較為全面的了解。
微生物實(shí)驗(yàn)室設(shè)備管理專(zhuān)題



12日下午13:30,由青島市食品藥品檢驗(yàn)研究院食品部 趙海峰 高級(jí)工程師帶來(lái)“微生物實(shí)驗(yàn)室設(shè)備管理”相關(guān)的精彩報(bào)告。
趙老師從設(shè)備的基本概念入手,詳細(xì)解析了實(shí)驗(yàn)室設(shè)備質(zhì)量控制、日常監(jiān)測(cè)與檢定的要求等內(nèi)容,并對(duì)大家比較關(guān)心的標(biāo)準(zhǔn)菌株、試劑耗材等方面的內(nèi)容進(jìn)行了詳細(xì)介紹,讓學(xué)員對(duì)于微生物實(shí)驗(yàn)室設(shè)備管理方面有了進(jìn)一步的了解。趙老師的講解耐心細(xì)致,得到了學(xué)員們的一直好評(píng)。
1.13日精彩內(nèi)容
實(shí)驗(yàn)室生物安全專(zhuān)題

13日上午09:00,由“野獸”老師帶來(lái)“實(shí)驗(yàn)室生物安全”的專(zhuān)題報(bào)告。實(shí)驗(yàn)室生物安全是實(shí)驗(yàn)室科研、檢測(cè)人員和社會(huì)大眾普遍關(guān)注的問(wèn)題,而針對(duì)實(shí)驗(yàn)室生物安全管理始終是我國(guó)生物安全管理的一個(gè)薄弱環(huán)節(jié)。


“野獸”老師從歷史上的感染事件、實(shí)驗(yàn)室生物安全管理現(xiàn)狀入手,講解了GB 19489 實(shí)驗(yàn)室生物安全通用要求、GB 50346生物安全實(shí)驗(yàn)室建筑技術(shù)要求、WS 233病原微生物實(shí)驗(yàn)室安全通則、WS589病原微生物實(shí)驗(yàn)室安全標(biāo)識(shí)等內(nèi)容,讓學(xué)員對(duì)實(shí)驗(yàn)室生物安全的相關(guān)標(biāo)準(zhǔn)內(nèi)容一個(gè)更新、更深層次的認(rèn)識(shí)。


“野獸”老師重點(diǎn)對(duì)生物安全柜的相關(guān)標(biāo)準(zhǔn),生物安全實(shí)驗(yàn)室的設(shè)備和實(shí)施的要求,生物實(shí)驗(yàn)室的設(shè)計(jì)原則、基本要求、生物安全標(biāo)識(shí)、良好操作規(guī)范要求及生物安全實(shí)驗(yàn)室自查、應(yīng)對(duì)等內(nèi)容進(jìn)行詳細(xì)解讀。聽(tīng)完以上講解,學(xué)員們表示老師講解的真好,受益匪淺!
微生物實(shí)驗(yàn)室能力驗(yàn)證專(zhuān)題

1月13日下午13:30,由揚(yáng)州市疾病預(yù)防控制中心 巢國(guó)祥 主任醫(yī)師帶來(lái)“微生物實(shí)驗(yàn)室能力驗(yàn)證”相關(guān)的精彩報(bào)告。

首先,巢老師詳細(xì)講解了能力驗(yàn)證的概念、作用、本質(zhì)、內(nèi)涵、能力驗(yàn)證結(jié)果評(píng)定及不滿(mǎn)意結(jié)果的處理要求。
然后從人員要求、檢驗(yàn)方法、實(shí)驗(yàn)設(shè)備及環(huán)境、檢驗(yàn)用品、培養(yǎng)基及試劑的質(zhì)量要求和測(cè)試方法、培養(yǎng)基保存、標(biāo)準(zhǔn)菌株的準(zhǔn)備及驗(yàn)證、檢測(cè)過(guò)程中各個(gè)步驟的注意事項(xiàng)、能力驗(yàn)證應(yīng)對(duì)等方面對(duì)“能力驗(yàn)證的過(guò)程”進(jìn)行了全面的深入講解。
老師憑借豐富的實(shí)驗(yàn)室經(jīng)驗(yàn),將實(shí)驗(yàn)室能力驗(yàn)證的重點(diǎn)難點(diǎn)內(nèi)容講解的深入透徹,學(xué)員們豁然開(kāi)朗,深受啟發(fā)。

至此,為期兩天的“食品微生物實(shí)驗(yàn)室技能提升培訓(xùn)班”線(xiàn)上課程完美收官!








